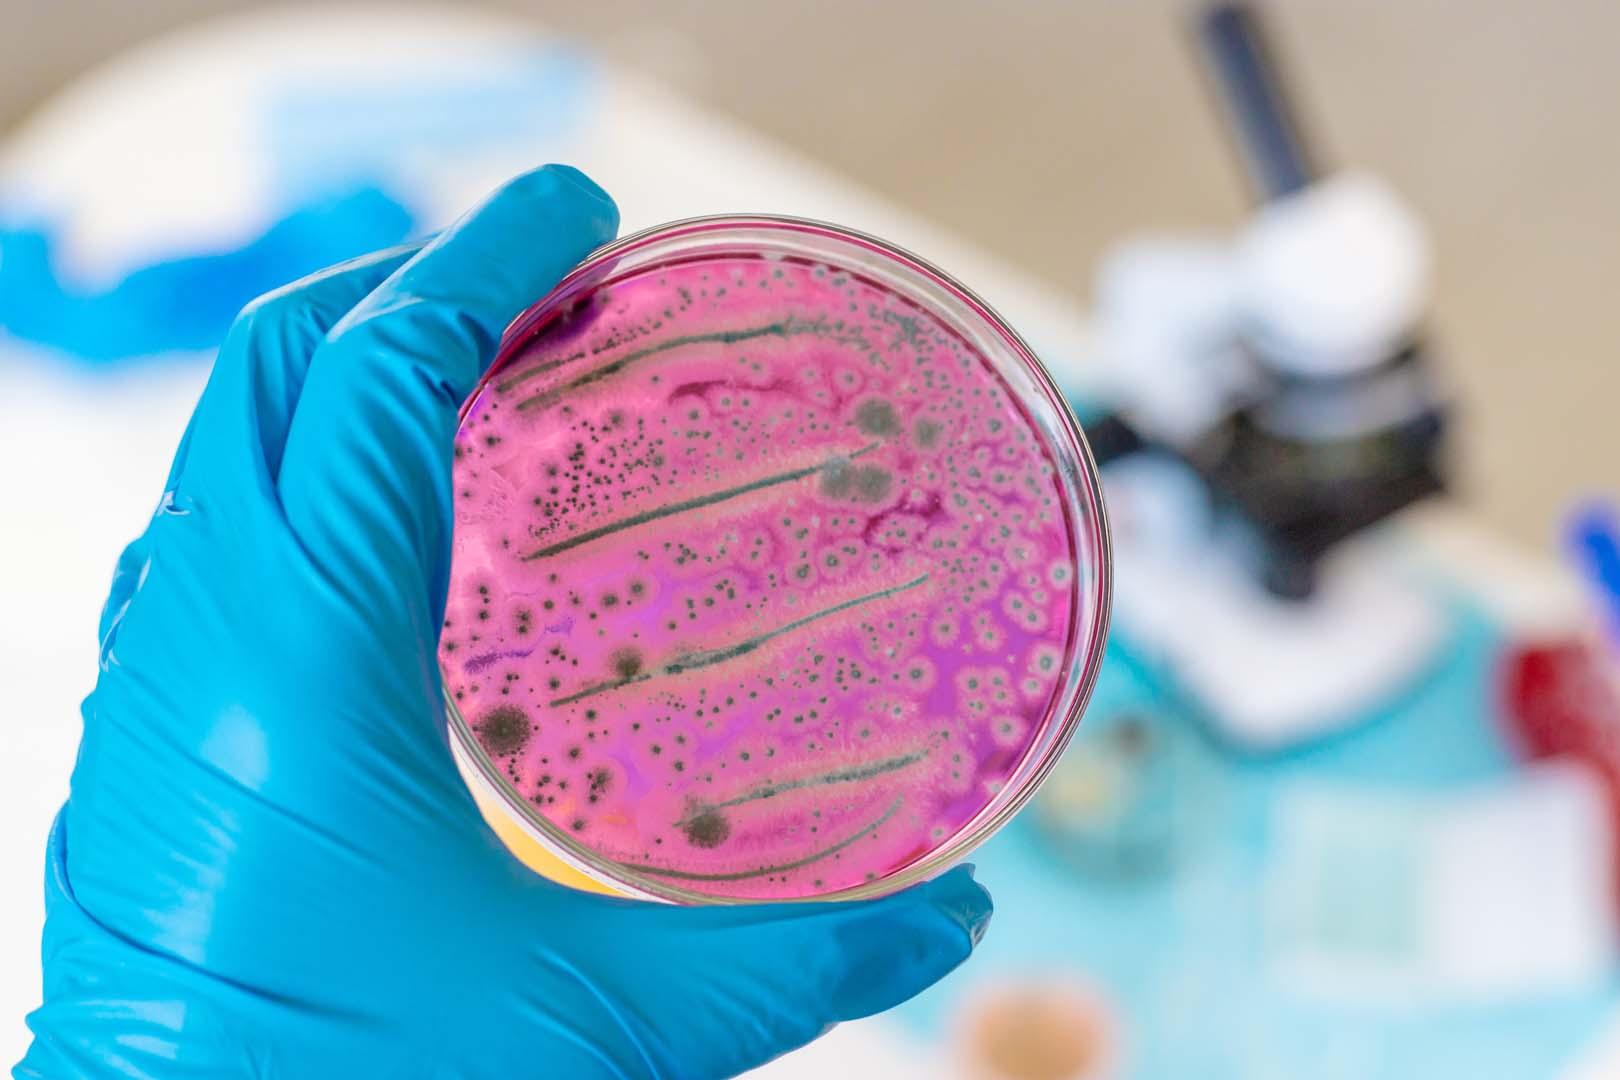

Görünmeyen tehlike! Bakteriler kimyasalları saklıyor
Bilim insanları, toprak ve su ekosistemlerinde PFAS olarak bilinen 'sonsuz kimyasalların' bakterilerin hücre zarlarına entegre olduğunu ortaya koydu. Araştırmada, PFAS'ın bakterilerde birikerek çevre için gizli bir tehdit oluşturduğu vurgulandı.
Bilim dünyası, PFAS adıyla bilinen ve çevrede uzun süre kalıcı olan kimyasalların toprak bakterilerinin hücre zarlarına doğrudan entegre olduğunu gösteren yeni bir araştırmayla sarsıldı. Earth dergisinde yayımlanan çalışmaya göre, bilim insanları bu kimyasalların yalnızca bakteriler tarafından tutulmadığını, aynı zamanda zar yapılarının ana bileşenlerine kadar işlendiğini belirledi. Araştırmada, yaygın bir toprak bakterisinin zarındaki ana moleküllerin yüzde 7 ila 12'sinin florlu kimyasal zincirlerle değiştirildiği tespit edildi. Benzer bir mekanizmanın Pseudomonas, E. coli ve insan bağırsağında bulunan Enterococcus faecalis türlerinde de gözlemlendiği bildirildi.
Bilim insanları: PFAS, bakteri zarında birikiyor
Çalışmada, normalde yağ asitlerini işleyen enzimlerin PFAS'ı florlu analoglara dönüştürdüğü ve bu kimyasalların bakteri zarında doğal kuyrukların yerine geçtiği ortaya çıktı. Uzmanlar, bu değişim sırasında bazı proteinlerin miktarında 3000 kat artış yaşandığını ve bunun bakterilerin PFAS'a karşı aktif bir adaptasyon geliştirdiğini gösterdiğini açıkladı. Araştırmacılar, 2,5 milyar parçaya kadar çıkan konsantrasyonlarda değiştirilmiş lipidler tespit etti. Ayrıca, ana bakteri suşunda eklenen test kimyasallarının yaklaşık yüzde 43'ünün zar bileşimine dahil olduğu belirtildi. Bu durum, PFAS'ın sıradan su analizlerinde kolayca tespit edilemeyen gizli bir kirlilik rezervuarı oluşturduğunu gösteriyor.
PFAS birikimi çevrede yeni riskler doğuruyor
Bilim insanları, PFAS'ın bakteri zarına entegre olmasının kimyasalların çevredeki yayılımını yavaşlattığını, fakat bu sürecin kirleticileri ortadan kaldırmadığını vurguladı. Zar hasar gördüğünde PFAS yeniden serbest kalabiliyor ve bu durum kimyasalın çevrede daha uzun süre kalmasına yol açıyor. Özellikle Enterococcus faecalis türünde gözlemlenen bu mekanizmanın, insan vücudunda da gerçekleşebileceği ihtimali endişe yaratıyor. Araştırmacılar, PFAS'ın toprak ve su yoluyla çevrede taşınmasının ötesinde, bakterilerle birlikte hareket ederek gözden kaçan bir tehdit oluşturduğunu belirtti. Bu bulgular, PFAS kirliliğine karşı mevcut analiz ve mücadele yöntemlerinin yeniden gözden geçirilmesi gerektiğine işaret ediyor.
Sonuç olarak, PFAS'ın bakterilerde birikimi çevre sağlığı açısından yeni ve karmaşık bir risk tablosu ortaya koyuyor. Bilim insanları, bu kimyasalların yayılımını ve etkilerini daha yakından takip etmek için kapsamlı araştırmalar yapılması çağrısında bulundu.
- Popüler Haberler -
"ABD, İran'ın nükleer programına 10 yıllık moratoryuma 'şartlı olarak istekli'"
Neden beygir gücü ile hesaplıyoruz? Otomotiv dünyasını nasıl değiştirdi?
Arjantin kongresinden Milei'nin buzul yasasına onay çıktı! Çevreciler ayakta
Bilim dünyası şaşkın! Felaket sandığımız şey çözüm mü?
Katar: Hürmüz krizi devam ederse bu bölgesel boyuttan çıkarak küresel bir hal alır
Sina'da 35 metre çapında gizemli yapı! Tarih yeniden yazılıyor



